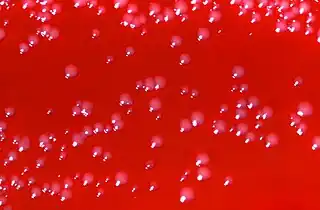

Arcanobacterium haemolyticum infection
| Arcanobacterium haemolyticum infection | |
|---|---|
| Other names: Corynebacterium haemolyticum[1] | |
![]() ![]() | |
| |
| Specialty | Infectious disease |
| Symptoms | Skin ulcers, abscesses,cellulitis,sore throat,fever[1][3] |
| Complications | Brain abscesses, endocarditis, and bacteremia[1] |
| Causes | A haemolyticum[1] |
| Diagnostic method | Culture, CAMP test[1] |
| Differential diagnosis | S. pyogenes, Mycoplasma pneumoniae, and Neisseria gonorrhea[1] |
| Treatment | Penicillin and macrolides [1] |
An Arcanobacterium haemolyticum infection is any of several types of infection with the gram-positive bacillus Arcanobacterium haemolyticum. It can cause an acute pharyngitis, and it may cause an exanthem characterized by an erythematous, morbilliform or scarlatiniform eruption involving the trunk and extremities.[4]: 268 [1]
In terms of management we find that penicillin and macrolides are prescribed[1]
Signs and symptoms

As to the presentation of Arcanobacterium haemolyticum infection we find:[1][5]
- Skin ulcers
- Abscesses
- Sore throat
- Headache
- Fatigue
Complications
In terms of the possible complications we find:[1]
- Brain abscesses
- Endocarditis
- Bacteremia
Cause
Arcanobacterium haemolyticum is a species of bacteria classified as a gram-positive bacillus. It is catalase-negative, facultative anaerobic, beta-hemolytic, and not motile.[6] It has been known to cause head and neck infections, pharyngitis, and sinusitis.[6]
Risk factors
In terms of risk factors that would place an individual at a higher possibility of A. haemolyticum infection we find:[1]
Diagnosis
As to the diagnosis of this infection we find that performing a throat swab culture on blood agar plates is the best way to determine the infection(37°C with 5 percent carbon dioxide for 1 to 2 days. [7]
-
Arcanobacterium haemolyticum after 48 hours -
CT chest shows multifocal cavitary lung lesions[5]
Differential diagnosis
_(52602981880).jpg)
In terms of the DDx we find that the following should be considered:[1]
- Epstein-Barr virus
- Measles
- Coronaviruses
- S. pyogenes
- Mycoplasma pneumoniae
- Neisseria gonorrhea
Treatment

As to treatment, we find that in light of the fact that resistance sometimes occurs, antimicrobial susceptibility testing is crucial. Penicillin and macrolides are most often prescribed [1]
Epidemiology
As to prevalence in the United States, A.haemolyticum is found in 0.4 percent of adults with pharyngitis . In Canada and Finland, has a similar incidence to the U.S. In Israel, Czechia, and Sweden, A.haemolyticum is found between 0.2% to 2% of individuals with pharyngitis .[8]
History
Arcanobacterium haemolyticum was first described by MacLean et al. in 1946. They identified it as a pathogen causing pharyngitis and soft-tissue infections among US servicemen and indigenous peoples of the South Pacific[8][9]
References
- ↑ 1.00 1.01 1.02 1.03 1.04 1.05 1.06 1.07 1.08 1.09 1.10 1.11 1.12 1.13 Vu, My Linh D.; Rajnik, Michael (2025). "Arcanobacterium haemolyticum Infections". StatPearls. StatPearls Publishing. Archived from the original on 2021-03-23. Retrieved 2025-02-01.
- ↑ "Details - Public Health Image Library(PHIL)". phil.cdc.gov. Retrieved 3 February 2025.
- ↑ "Arcanobacterium Haemolyticum Clinical Presentation: Physical Examination". emedicine.medscape.com. Archived from the original on 31 May 2024. Retrieved 9 February 2025.
- ↑ James, William D.; Berger, Timothy G.; et al. (2006). Andrews' Diseases of the Skin: clinical Dermatology. Saunders Elsevier. ISBN 0-7216-2921-0.
- ↑ 5.0 5.1 Alrwashdeh, Anas M.; Saluja, Prachi; Hasan, Lana; Kocurek, Emily; Dare, Ryan K. (1 January 2023). "Arcanobacterium haemolyticum bacteremia presenting as severe sepsis: A case report and review of the literature". IDCases. 31: e01645. doi:10.1016/j.idcr.2022.e01645. ISSN 2214-2509. Archived from the original on 22 December 2022. Retrieved 27 February 2025.
- ↑ 6.0 6.1 Paller, Amy S.; Mancini, Anthony J. (1 January 2016). "16 - Exanthematous Diseases of Childhood". Hurwitz Clinical Pediatric Dermatology (Fifth ed.). Elsevier. pp. 382–401.e4. ISBN 978-0-323-24475-6.
- ↑ "Arcanobacterium Haemolyticum Workup: Laboratory Studies". eMedicine. 6 February 2025. Archived from the original on 17 May 2022. Retrieved 7 February 2025.
- ↑ 8.0 8.1 "Arcanobacterium Haemolyticum: Practice Essentials, Pathophysiology, Epidemiology". eMedicine. 6 February 2025. Archived from the original on 29 December 2008. Retrieved 8 February 2025.
- ↑ MacLean PD, Liebow AA, Rosenberg AA. A hemolytic Corynebacterium resembling Corynebacterium ovis and Corynebacterium pyogenes in man. J Infect Dis. 1946. 79:69-90.
External links
| External resources |
|---|